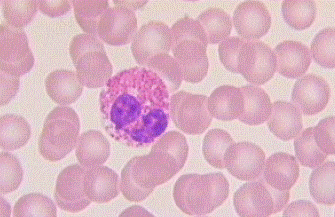
granulocyte

Liens vers les autres tissus:
--- ADHERENCE et COMMUNICATION CELLULAIRE --- TISSU EPITHELIAL --- TISSU CONJONCTIF --- TISSU MUSCULAIRE --- TISSU NERVEUX ---
1- Définition.
Les tissus conjonctifs (TC) sont des tissus dont les cellules sont séparées par de la matrice extracellulaire, contrairement aux épithéliums où les cellules sont jointives.
Le tissu conjonctif est le tissu le plus répandu dans le corps. Il unit, soutient, protège et isole les organes du corps. C’est un tissu innervé et irrigué (sauf le cartilage).
- Fonction.
- Assure la connexion de l’épithélium au reste de l’organisme (lame basale).
- Rôle essentiel de liaison métabolique : milieu dans lequel tous les nutriments et les déchets diffusent au cours de leur transit entre le sang et les cellules.
- Rôle de structure (os, cartilage)
- Stocke énergie (tissu adipeux)
- Transport de matières (sang)
- Composition.
Les tissus conjonctifs sont constitués de deux composantes:
- Cellules
- Matrice extracellulaire (MEC), qui est elle-même composée de deux composantes:
--- Fibres (collagène, élastine)
--- Substance fondamentale (liquide ou solide) faite d’eau, de molécules dissoutes, de macromolécules, les proteoglycanes, les glycoprotéines de structure.
1- Cellules du tissu conjonctif
-- 1-1-Les cellules fixes : (Blaste = cellule en croissance. cyte = phase quiescente de la cellule)
---- a- Les cellules mésenchymateuses ou cellules souches, qui se différencient en plusieurs types de cellules de soutient (fibroblastes, adipocytes, chondroblastes et ostéoblastes….) Ces cellules sont fusiformes ou étoilées et possèdent un gros noyau
---- b- Les fibroblastes : produisent les fibres de la matrice extracellulaire. Ce sont les cellules les plus nombreuses du tissu conjonctif ordinaire. les fibroblastes ont une forme irrégulière et leur cytoplasme est tellement pâle qu'on n'en voit souvent que le noyau ovoïde. Leurs principales sécrétions sont le procollagène, la proélastine, et des glycosaminoglycans et protéoglycans incorporés à la substance amorphe.

---- c- Les Macrophages : sont des grandes cellules en formes irrégulières, ramifiées. Elles sont des phagocytes dérivés des monocytes.

---- d- Les Mastocytes sont des cellules qui sécrètent l’histamine (substance qui dilate les petits vaisseaux sanguins durant les inflammations.) Ces cellules sont fusiformes avec un noyau granuleux.

---- e- Les Adipocytes : accumulent du gras. Les cellules sont rondes ou ovales, le noyau et le cytoplasme sont périphériques. Le cytoplasme est clair car la graisse se dissout durant la préparation.
---- f- Les chondroblastes et les chondrocytes sont présents dans les cartilages.
---- g- Les ostéoblastes et les ostéocytes sont présents dans les os.
-1-2- Les cellules libres (Les globules blancs)
---- a- Les lymphocytes : sont à l’origine des réponses immunitaires spécifiques. Elles sont rondes et possèdent des grands noyaux ovoïdes.
---- b- Les plasmocytes : grosses cellules rondes, au noyau excentré contenant une chromatine condensée souvent périphérique, et au cytoplasme basophile abondant. Elles dérivent des lymphocytes et sécrètent des immunoglobulines.

---- c- Les monocytes circulants
---- d- Les polynucléaires :
---- Les neutrophiles sont très importants dans la réponse inflammatoire aiguë
---- Les basophiles sont les précurseurs des mastocyte
---- Les éosinophiles augmentent dans les infestations parasitaires et dans les allergies.

2- Substance fondamentale
La substance fondamentale n'a pas de forme. Elle peut exister à l'état aqueux, le fluide intercellulaire, ou à l'état de gel visqueux semi-fluide.
Elle provient surtout des capillaires artériels et sa composition ressemble à celle du plasma, avec des variations biochimiques locales. Elle permet la diffusion de l’oxygène et des molécules dissoutes dans l’eau. Elle est faite d’eau, de molécules dissoutes, de macromolécules, les proteoglycanes, des glycoprotéines de structure et des protéines de liaison.
La substance fondamentale joue plusieurs rôles:
- un filtre moléculaire qui stoppe l’étendue de substances nocives
- rôle important dans la nutrition cellulaire et l’élimination des déchets
- rôle vital dans le vieillissement car elle diminue avec l’âge.
3- Fibres du tissu conjonctif
Trois types de fibres procurent force et soutien aux tissus.
Les Fibres sont formées de protéines fibrillaires sécrétées par des cellules du tissu conjonctif, principalement par des fibroblastes. Elles peuvent être sécrétées par des cellules épithéliales ou par des muscles lisses.

--- 3.1- Les fibres de collagène (1 à 12 micromètre) : donnent au tissu sa résistance. Ces fibres sont les plus communes, elles sont flexibles et résistent aux forces de tension dans les tissus.
On connaît 19 types de collagène différents.
Les fibroblastes synthétisent des molécules de procollagène qu'ils sécrètent à leur surface, où elles sont converties en molécules de tropocollagène qui s'assemblent en fibrilles de collagène, ces dernières s'apposent pour finalement former les fibres de collagène, qui peuvent atteindre jusqu'à 10 μm de diamètre et qui ne sont pas embranchées.

--- 3.2.- Les fibres réticulaires (fibres de réticuline): sont composées de la protéine collagène mais contiennent davantage de carbohydrates que les fibres collagéniques mêmes (type III collagène). Ce sont de fines fibres embranchées qui forment des réseaux délicats; elles jouent un rôle de soutien léger, par exemple en association avec des capillaires, fibres nerveuses ou musculaires, glandes et organes lymphatiques.
Les fibrilles de réticuline ne s'associent pas en faisceaux, elles forment un grillage délicat de fibrilles très fines (0.2-1.0 μm de diamètre) entrecroisées.

--- 3.3.- Les fibres élastiques : (0,2 à 2 micromètre) Elles sont composées d’une protéine appelée élastine, ces fibres se ramifient et se rejoignent. Elles confèrent la force et peuvent être étirées sans se déchirer, permettent la dilatation et l’expansion. Elles se rétractent après étirement. Elles sont présentes dans différentes régions tel que les poumons, les ligaments, les tendons, les vaisseaux, les cartilages et le derme de la peau, les artères élastiques.

4- Classification
On classe les tissus conjonctifs (TC) selon la prédominance d'un de ces trois constituants en trois variétés de tissus conjonctifs:
- les tissus conjonctifs proprement dits à une MEC fluide et fibreuse:
--- tissu conjonctif lâche,
--- tissu réticulaire,
--- tissus conjonctifs denses,
--- tissu élastique ou
--- très cellulaire (tissu adipeux).
- le TC à MEC solide et déformable, le tissu cartilagineux.
- le TC à MEC solide, rigide et minéralisée, le tissu osseux.
- Les Tissus conjonctifs non spécialisés
TC embryonnaire
--- mésenchymateux
--- gélatineux
TC réticulé
TC fibreux
--- lâche
--- dense :
----- oriente
----- non oriente
----- élastique.
- Les tissus conjonctifs spécialisés
TC adipeux
Tissus squelettiques :
--- tissus cartilagineux
--- tissus osseux
Tissu sanguin
A- TISSUS CONJONCTIFS NON SPECIALISES:
Les tissus conjonctifs non spécialisés constituent le soutien et le lien entre les autres tissus de l'organisme. Ils incluent:
- le tissu mésenchymateux,
- le tissu conjonctif gélatineux,
- le tissu conjonctif fibreux lâche,
- le tissu conjonctif fibreux dense (orienté ou non orienté) et
- le tissu réticulaire.
Ces tissus sont composés de cellules (comme les fibroblastes et les cellules mésenchymateuses) et d'une matrice extracellulaire.
1-Tissu conjonctif embryonnaire
--- 1- Tissu mésenchymateux: présent dans l’embryon, il donne naissance à tous les autres tissus conjonctifs. Les cellules sont irrégulières, la substance fondamentale est semi-liquide et les fibres sont réticulées.
--- 2- Tissu conjonctif gélatineux (ou TC muqueux 'LA GELEE DE WARTHON') : c’est un Tissu quiescent localisé au niveau du cordon ombilical et placenta. La MEC est constitué de protéoglycanes et fibres de collagène. Les cellules mésenchymateuses sont en réseau. Le tissu est caractérisé par la prédominance de la substance fondamentale.
2- Tissu conjonctif adulte
--- 1- Le tissu conjonctif lâche
Tissu présent partout où il faut de la résistance : peau, vaisseaux sanguins, coeur, intestin, nerf, muscles, etc. Équilibrée en cellules, fibres et substance fondamentale.

Le rôle du tissu conjonctif lâche :
le tissu conjonctif possède un rôle de soutien et d’emballage des tissus et organes
il assure le passage de nombreuses substances entre le sang et les tissus
il joue un rôle majeur dans les réactions inflammatoires et dans les phénomènes immunitaires
ainsi que dans les processus de cicatrisation (par prolifération des fibroblastes et production des macromolécules de la MEC).
--- 2- Tissu conjonctif dense (fibreux)
Cette variété est caractérisée par une prédominance très nette des fibres de collagène au détriment des autres constituants.
Les tissus conjonctifs denses sont riches en fibres, pauvres en cellules et en substance fondamentale. Ils ont une fonction essentiellement mécanique. Il s’agit du tissu conjonctif fibreux dense et tissu élastique
tissu conjonctif fibreux dense
Ils contiennent essentiellement des fibres parallèles de collagène et ils se répartissent en deux sous-groupes, les tissus conjonctifs denses non orientés et orientés:
- les tissus conjonctifs fibreux non orientés:

Les fibres de collagène sont sans orientation précise (Fibres entrecroisées). Ce tissu conjonctif est observé au niveau des parois conjonctives délimitant les organes pleins (dont le foie, la rate, les reins, ..), dans les capsules articulaires et au pourtour de l’os (périoste).
- les tissus conjonctifs denses (fibreux) orientés:
Les fibres forment des faisceaux parallèles. Cellules peu nombreuses alignées entre les faisceaux.
-- A– Tissu conjonctif dense (fibreux) uni tendu : Toutes les fibres ont la même direction ex: ligaments et tendons,

-- B- Tissu conjonctif dense (fibreux) bitendu :
Les fibres de chaque plan sont perpendiculaires aux fibres des plans adjacents. Couches superposées d’orientation différente. Ex: stroma de la cornée.

C. Les tissus conjonctifs élastiques
Les fibres élastiques y prédominent largement, entre de rares fibroblastes ou entre les cellules musculaires lisses (comme dans la média des artères de gros calibre). Se trouvent seulement dans les ligaments jaunes, le ligament de la nuque, les ligaments vocaux et le ligament suspenseur du pénis.

--- D- Le tissu conjonctif réticulaire
Le tissu réticulaire (ou réticulé) correspond au tissu conjonctif qui constitue la trame de soutien des organes hématopoïétiques et lymphoïdes (ganglions lymphatiques, rate, moelle osseuse), du foie et du rein. Sa charpente collagène, principalement faite de collagène de type III : réticuline. En ME, le collagène III apparaît sous forme de fins microfilaments apériodiques, dispersés dans une matrice riche en protéoglycanes. Il est caractérisé par la prédominance des fibres de réticuline.

2- TISSUS CONJONCTIFS SPECIALISES
1- Tissu conjonctif adipeux
Tissu conjonctif lâche envahi par des cellules adipeuses (adipocytes).

Il y a deux types de tissu adipeux :
La graisse blanche chez les adultes: Cellule sphérique, noyau petit, dense et refoulé en périphérie.
Cytoplasme réduit à une mince enveloppe qui contient de nombreuses mitochondries et un appareil de golgi.
Grosse vacuole de graisse non entourée de membrane.
La graisse brune est présente chez les foetus et les enfants. Elle possède des petites adipocytes, une riche vascularisation (maintient la température appropriée) : C’est une cellule polyédrique, noyau central, cytoplasme contient un très grand nombre de vacuoles lipidiques de petite taille. Elle est présente dans:
- la région inter scapulaire
- Autour des gros vaisseaux
- Autour des reins et du coeur
Rôle du tissu Conjonctif adipeux :
• Réserve d’énergie
• Protection mécanique (les reins, par exemple, sont entourés d'une gaine de gras qui les protège)
• Isolant thermique (chez les oiseaux ou mammifères marins).
2- Tissu cartilagineux
C’est un tissu conjonctif spécialisé, squelettique, à une forme semi-rigide ; Comme pour le tissu osseux, la consistance du tissu cartilagineux est dure, mais contrairement à l'os, le cartilage n'est pas minéralisé.
Le cartilage est un tissu conjonctif formé par des cellules, les chondrocytes, de forme arrondie, généralement incluses dans des logettes, ou chondroplastes ; au sein d'une matrice extracellulaire constituée de fibres de collagène (principalement des fibres de type II, spécifiques de ce tissu), enrobées d’une substance fondamentale solide: chondroïtine-phosphate.
Le cartilage est dépourvu de vascularisation et d’innervation.
Il sert de support, facilite les mouvements et joue un rôle important dans l’ossification.
Le cartilage recouvre les articulations et forme certaines parties souples du corps comme l'extrémité du nez ou le larynx (la "pomme d'Adam") et le pavillon de l’oreil.
3- Tissu osseux
Le tissu osseux est formé de cellules (les ostéoblastes), les fibres de collagène (flexibilité) et une substance fondamentale avec des minéraux, phosphate et calcium (rigidité).
C'est un tissu de soutien en constant renouvellement.
Contient de nombreux vaisseaux sanguins. Le squelette a trois fonctions :
-Mécanique : locomotion.
-Métabolique : réserve en calcium et en phosphore.
-Hématopoiétique : il renferme la moelle osseuse.
4- Tissu sanguin.
Le sang est un tissu conjonctif spécialisé, composé de cellules (les éléments figurés 45%) réparties dans un liquide (le plasma 55%). L'ensemble est véhiculé dans les vaisseaux sanguins et son volume est de 5L.
Le plasma est constitué de protéines (albumine, globulines), d'enzymes, de lipides, de glucides, d'ions et de sels minéraux, de vitamines, de gaz dissous et d'eau.
Les éléments figures du sang regroupent 3 types de cellules :
- Les globules rouges (ou hématies)
- Les globules blancs (ou leucocytes)
- Les plaquettes (ou thrombocytes)
Le rôle du tissu sanguin est :
- Transport des gaz respiratoires (par les hématies), les hormones, éléments nutritifs (par le sérum).
- Défense de l’organisme (par les leucocytes)
- La cicatrisation et l’hémostase : arrêt de l’hémorragie par les thrombocytes.
-------------------------------------------------
Le critère retenu pour la classification des différents types de tissus conjonctifs est l'importance relative des trois constituants de base :
- les cellules,
- les fibres et
- la substance fondamentale.
A partir de ces données, trois grands groupes de tissus conjonctifs sont identifiés :
• Les tissus conjonctifs lâches, plutôt riches en cellules par rapport aux fibres
• Les tissus conjonctifs denses, plutôt riches en fibres par rapport aux cellules. Il en existe quatre sous-types :
--- non orientés,
--- orientés,
--- élastiques et
--- réticulés
• Les tissus conjonctifs spécialisés dans lesquels la substance fondamentale est particulière : tissus osseux, tissus cartilagineux, tissus adipeux et tissu sanguin.

TISSU CARTILAGINEUX
Le tissu cartilagineux est un tissu conjonctif qui est d’origine mésenchymateuse, il est constitué de cellules appelées les chondroblastes et les chondrocytes. Tissu élastique et
solide, compact, translucide, déformable, non minéralisé.
Sert de support, facilite les mouvements et joue un rôle primordial dans l’ossification.
Est dépourvu de vascularisation et d’innervation.
Sa localisation dépend de l’âge:
- Foetus : constitue la plus grande partie du squelette
- Adulte : cartilage hyalin, élastique et fibro-cartilage
- Maturité : cartilage de conjugaison
Les chondrocytes sont associés à des fibres et à une substance fondamentale. L’ensemble
des fibres et de la substance fondamentale constitue la matrice extra-cellulaire du tissu
cartilagineux.
Le cartilage est entouré en dehors des surfaces articulaires d’une enveloppe
conjonctive appelé périchondre.
Le tissu cartilagineux est composé de:
- Cellules appelées chondroblastes et chondrocytes
- Substance inter cellulaire fondamentale solide et élastique
- Des fibres
1. Les chondroblastes
Ce sont des cellules ovoïdes avec un noyau central avec une chromatine claire, et on
retrouve un REG abondant, un appareil de Golgi proche du noyau (juxta-nucléaire), des
vésicules et des vacuoles, des mitochondries, des ribosomes libres, des inclusions lipidiques
et de glycogène. Ce sont des cellules jeunes et très actives.
2. Les chondrocytes
Ce sont des éléments plus matures présentant une morphologie sensiblement identique au
chondroblaste. Les chondrocytes possèdent des organites cellulaires moins développés et
ils sont moins actifs. Ils sont logés dans des cavités creusées dans la substance fondamentale appelées chondroplastes.

3. La substance fondamentale
Elle est homogène, translucide, de consistance visqueuse, résistante et élastique, elle enveloppe les cellules et la trame fibrillaire. La substance fondamentale comporte de l’eau, des sels minéraux, des protéoglycanes, des glycoaminoglycanes "la chondroitine
sulfate", des protéoglycanes.
Elle contient aussi des enzymes protéolytiques permettant la dégradation de la matrice au
cours de son renouvellement
4. Les fibres
Ce sont des fibres de collagènes (I, II, IX et XI) d’abondance variable noyées dans la
substance fondamentale et se disposent volontiers de manière circulaire autour de
plusieurs cellules cartilagineuses.
- Le collagène de type II se retrouve dans le cartilage hyalin
- Le collagène de type I se retrouve dans le fibro-cartilage
- Les fibres élastiques se retrouvent dans le cartilage élastique
5. Les variétés de tissu cartilagineux
3 variétés de tissu cartilagineux sont classés selon
- La quantité de substance fondamentale
- L’abondance et la disposition de fibres de collagènes
- La présence de fibres élastiques.
De ce fait on distingue:
- Le Cartilage hyalin
- Le Cartilage élastique
- Le fibro-cartilage
5.1. Le cartilage hyalin
C’est le plus répandu et il est localisé au niveau des cartilages articulaires, des
cartilages trachéo-bronchiques, de la cloison nasale, ainsi qu'au niveau
des cartilages intercostaux. La matrice y contient différents types de collagène mais
majoritairement du collagène type II.

5.2. LE CARTILAGE ÉLASTIQUE
C’est un cartilage particulier dans la mesure où sa matrice contient de nombreuses fibres
élastiques associées aux fibres de collagène. Ces fibres donnent une grande souplesse au tissu
qui peut supporter de légères déformations qui seront toujours réversibles. Ce cartilage se
trouve dans le pavillon de l’oreille, au niveau du conduit auditif externe, de l’épiglotte et
du larynx.
Au microscope il apparaît jaunâtre et présente une assez grande densité cellulaire
(chondrocytes). Ces chondrocytes contiennent souvent d’assez volumineuses inclusions
lipidiques.

5.3. Le cartilage fibreux
Le cartilage fibreux ou fibrocartilage fournit une très grande résistance aux tractions et
pressions. On le trouve au niveau des disques intervertébraux, de la symphyse pubienne,
des ménisques, articulation de la hanche et de l’épaule
La matrice va contenir des fibres de collagène de type I (en telle quantité qu’elles sont visibles
en MO avec les colorations de routine).
Les chondrocytes ont un aspect particulier : tendance à être fusiformes, ne comportent pas
d’inclusions lipidiques. Ces chondrocytes vont être entourés d’une zone péri-cellulaire
totalement dépourvue de fibres, contenant uniquement la substance fondamentale.

6. Le périchondre.
Il est représenté autour des pièces de cartilage. Il se dispose sous la forme d’un tissu
conjonctif d’épaisseur variable (en moyenne 300μ). Il englobe tous les types de cartilage sauf
l’articulaire.
Ce tissu conjonctif adhère fortement aux cartilages hyalin et élastique, il est responsable de la
nutrition et de la croissance.
Histologiquement, on distingue une couche externe relativement fibreuse, très richement
vascularisée. Cette couche est aussi appelée couche nourricière.

La couche interne est beaucoup plus cellulaire, assez peu vascularisée. Elle a un rôle dans la croissance et dans la réparation des pièces cartilagineuses : elle est appelée couche
chondrogène. Ce sont les cellules présentes dans cette couche qui deviennent de nouveaux
chondrocytes. On a de fines fibres de collagène qui attachent le périchondre à la pièce
cartilagineuse.
7. Le cartilage articulaire
C’est un cartilage hyalin formant la limite des cavités articulaires. Ce cartilage est disposé au
niveau de la surface des pièces osseuses. Le cartilage permet le mouvement d’une pièce
osseuse par rapport à l’autre et de supporter le poids du corps.
8. Croissance des cartilages
La croissance du cartilage s’effectue selon une double modalité :
8.1. Croissance interstitielle
La croissance dite interstitielle s’effectue par mitoses successives des chondrocytes euxmêmes.
Dans ce cas, les cellules filles d’un même clone cellulaire s’éloignent de la cellule
mère en se disposant soit de manière rectiligne soit de manière circulaire. Elles forment ce
qu’on appelle des groupes isogéniques axiaux ou coronaires. Ces différentes dispositions
permettent la croissance axiale ou circonférentielle du cartilage. On peut au cours de ce
processus observer la présence de plusieurs chondrocytes au sein du même chondroplaste.
La
croissance interstitielle est observée chez le foetus mais également au cours de la croissance
osseuse post-natale des os long.

En effet jusqu’à la puberté, la métaphyse des os longs renferme un cartilage de croissance nommé cartilage de conjugaison et qui participe à la croissance osseuse.
8.2. Croissance par apposition
Les cellules du périchondre ressemblent aux fibroblastes. Elles produisent le collagène type
I du périchondre. Cependant, durant la croissance par apposition, les cellules de la couche
profonde du périchondre se transforment en chondroblastes, et sécrètent autour d'elles du
collagène type II ainsi que la matrice cartilagineuse. Les chondroblastes, se transforment en
chondrocytes.

TISSU OSSEUX
Les os de l'organisme peuvent être classés en quatre types principaux selon leur forme
- les os longs,
- les os courts,
- les os plats
- les os irréguliers.Les os longs
Un os long comprend trois parties:
- Les épiphyses : ce sont les deux extrémités. Elles
sont constituées d’os spongieux ou trabéculaire.
- La diaphyse : est la partie médiane des os longs. C’est un cylindre creux d’os compact à orientation longitudinale. La cavité centrale, ou cavité médullaire, renferme la moelle osseuse.
- Les métaphyses : ce sont des segments coniques situés entre les épiphyses et la
diaphyse. Les os longs sont constitués surtout de tissu osseux compact, mais ils contiennent aussi une quantité importante de tissu osseux spongieux

1. Structure générale des tissus osseux
L’aspect architectural des tissus osseux est très différent d’un type à l’autre.
1-1- Tissu osseux réticulaire (non lamellaire).
Il est de type fibreux, souvent appelé os immature. Il est mécaniquement faible. Les cellules
de ce tissu sont nombreuses et disposées sans ordre. La matrice est peu minéralisée, contient
des faisceaux de fibres de collagène à disposition aléatoire.
Ce type de tissu osseux existe au
cours de développement.
Il a généralement une durée de vie courte car il est destiné à être
remplacé assez rapidement par un tissu osseux lamellaire.
Il est élaboré à partir de cartilage ou
de tissu conjonctif.

1-2- Le tissu osseux trabéculaire ou os spongieux
Il est constitué par un réseau de trabécules de tissu osseux :
• ramifié et anastomosé;
• délimitant des espaces intercommunicants occupés par la moelle osseuse hématopoïétique
(multiples cavités médullaires) ainsi que par des vaisseaux.
Le tissu osseux spongieux
diffère du tissu osseux compact par la taille et le nombre de ces cavités.
Les lamelles osseuses
sont organisées, dans ce cas, autour des cavités et sont disposées irrégulièrement.
Exemple de tissu osseux spongieux : épiphyses des os longs, Diploé des os plats

1-3- le tissu osseux haversien ou compact.
Dans le tissu osseux compact, les lamelles osseuses forment des ensembles circulaires
nommés ostéones ou système de Havers. Chaque ostéone est centré par un canal, le canal
de Havers, au sein duquel circulent des capillaires sanguins et des fibres nerveuses amyéliniques (sensitives et végétatives).
Les ostéones sont séparés par des ostéones incomplets qui dérivent de la résorption partielle
d’ostéones. Les lamelles osseuses formant ces ostéones incomplets sont nommées lamelles
osseuses interstitielles.

Par ailleurs, les ostéones sont reliés les uns aux autres ainsi qu’avec la surface de l’os par des canaux transversaux, les canaux de Volkman. Ceux-ci confèrent une résistance maximale au tissu osseux, en répartissant les forces de pression.
Le tissu osseux compact est localisé au pourtour des os courts (vertèbres), dans les tables internes et externes des os plats (os du crâne, sternum) ainsi qu’au pourtour de la diaphyse et de l'épiphyse des os longs (tibia, fémur...).
Enfin, le tissu osseux compact de la diaphyse des os longs présente 2 caractéristiques
supplémentaires :
- les ostéones sont bordés par des lamelles osseuses parcourant la circonférence externe
et interne du tissu osseux compact : il s’agit des systèmes circonférentiels internes et
externes,
- les canaux de Volkman relient les ostéones à une cavité osseuse centrale, la cavité
médullaire, qui contient du tissu adipeux nommé moelle osseuse jaune.
1-4- le tissu conjonctif associé au tissu osseux :
Qu’il s’agisse de tissu osseux mature ou immature, les surfaces osseuses externes et
internes sont recouvertes de tissu conjonctif non spécialisé.
- Le périoste
Le périoste est une membrane continue, enveloppant dans presque toute son étendue la
surface extérieure des os, presque toute son étendue, car il fait défaut an niveau des tendons et
des ligaments.
Le périoste manque encore sur les parties que revêt le cartilage articulaire et les
os sésamoïdes.
Il est responsable de la croissance, du développement et de la forme des os.
Il est également responsable de la réparation des dommages que les os peuvent subir.
Le périoste est formé de deux couches, une externe fibreuse et une interne responsable de la
croissance des os.
● Couche externe ou fibreuse
C'est la couche la plus éloignée de l'os. C'est une couche de tissu conjonctif. Il contient des
fibroblastes et des fibres de collagène. Ces fibres sont produites par les fibroblastes.
Les fibroblastes sont des cellules dérivées de cellules mésenchymateuses. Cette couche est
également très vascularisée et possède des terminaisons nerveuses.
● Couche interne ou ostéogène
C'est la couche la plus interne et est en contact avec l'os. Il contient des cellules ostéogènes et
est vascularisé.
Les cellules ostéogènes peuvent être différenciées en deux types de cellules:
-- les ostéoblastes.
-- les chondroblastes.
Les deux types de cellules jouent un rôle fondamental dans la croissance des os. Ils aident
également à réparer les blessures subies par les os.
- l’endoste,
C'est un tissu conjonctif tapissant toutes les parois des cavités vascularisées des os
(canaux de Havers, canaux de Volkmann, cavité médullaire de l'os compact).


2- Composition de l’os
Le tissu osseux, comme le cartilage, est un tissu conjonctif spécialisé ou squelettique. Il comporte :
● Une matrice extracellulaire (MEC) minéralisée qui confère au tissu osseux sa rigidité et sa solidité (substance fondamentale, des fibres)
● Des cellules osseuses (cellules bordantes, ostéoblastes, ostéocytes, ostéoclastes)
● Parcouru par un très riche réseau vasculaire.
Le tissu osseux est fait de cellules osseuses noyées dans une matrice osseuse.
2-1- La matrice osseuse
Elle est constituée d'une partie organique, d'une partie minérale et de l'eau (le tissu le moins
hydratée de l’organisme).
2-1-1- Partie organique
Egalement appelée ostéoïde avant sa minéralisation, la matrice organique est faite de :
• collagène (essentiellement de type I) : très abondant 90 à 95% de la fonction organique,
souvent de type I.
• substance fondamentale :
- glycoprotéines non collagènes spécifiques de l’os (10%) dont :
-- l'ostéonectine : c'est la plus abondante. lié au collagène et aux sels minéraux (cristaux
d’hydroxyapatite). Elle sert de colle entre les parties minérales et les parties organiques.
-- l'ostéocalcine : elle intervient dans la minéralisation osseuse (marqueur des ostéoblastes
matures).
-- l'ostéopontine.: relie l'hydroxy-apatite aux cellules osseuses.
-- protéoglycanes : ils sont présents dans l'ostéoïde mais rares. (avec des GAG de type chondroitine sulfate et kératane sulfate)
- eau et électrolytes.
2-1-2- Partie minérale
La matrice minérale est responsable de la rigidité de l'os, les minéraux se fixent sur la trame
protéique de l'ostéoïde. Les minéraux les plus importants sont :
• le calcium
• le phosphore
• le sodium
• le Potassium
• le Magnésium
La matrice organique se minéralise par des dépôts de phosphate et de calcium cristallisés,
formant des cristaux d'hydroxyapatite (apatite hydratée) Ca10(PO4)6(OH)2.
2-2- Cellules osseuses
Le tissu osseux adulte apparaît formé des cellules suivantes:

2-2-1- Ostéoblastes
- Aspect au microscope optique : Ce sont des cellules polyédriques ; prismatiques
munies de nombreuses et longues expansions cytoplasmiques recouvrant la surface
externe et interne de l’os, de 20 à 30 microns, possèdent :
• un noyau arrondi le plus souvent excentré pourvu d'un gros nucléole;
• un cytoplasme basophile riche en ARN, glycogène, vitamine C, phosphatases.

- Aspect au microscope électronique :
Elles présentent un aspect caractéristique de cellules.
activement engagées dans la synthèse de protéines. On observe :
• un ergastoplasme très développé, avec des ribosomes libres
• un appareil de Golgi très important;
• des mitochondries ovoïdes nombreuses riches en granules de phosphates calciques (elles
sont capables de stocker de grandes quantités de calcium et de phosphate)
• Vacuoles dont le contenu est amorphe : muco- polysaccharides
• Inclusions lipidiques
• Lysosomes Les ostéoblastes sont unis par des jonctions de type gap et sont séparés de la
matrice osseuse par une substance amorphe non encore calcifiée.
- Cytophysiologie Les ostéoblastes interviennent dans l'élaboration de la matrice organique
et sa minéralisation. Il a été décrit la présence de récepteurs à la surface des ostéoblastes pour
certaines hormones, vitamines et cytokines qui régulent leurs activités. Une fois l'ostéoblaste
complètement enfoui dans la matrice minéralisée, il devient un ostéocyte emprisonné dans
des lacunes au sein de la substance nouvellement synthétisée (ostéoplastes)
2-2-2- Cellules bordantes
Ostéoblastes au repos Elles sont aplaties, allongées, possédant peu d’organites, reliées entre
elles avec les ostéocytes voisins. Les cellules bordantes peuvent, lorsqu'elles sont sollicitées,
redevenir des ostéoblastes actifs.
2-2-3- Ostéocytes
- Aspect au microscope optique : Ce sont des cellules fusiformes et étoilées (d'une taille
de 15 μm) contenues dans des logettes appelées ostéoplastes. ces lacunes sont reliées par
de nombreux prolongements contenus dans des canalicules (interostéoplastiques). Entre
la paroi de l’ostéoplaste et l’ostéocyte, existe une un mince espace périostéocytaire non
minéralisé, ou on retrouve des fibres de collagènes et une forte concentration de
protéoglycanes. Ces cellules renferment :
• un noyau aplati à chromatine homogène;
• un cytoplasme peu abondant, légèrement acidophile car les organites intracellulaires
sont moins développés que dans l'ostéoblaste.

Elles possèdent :
• un noyau ayant l'ultrastructure habituelle avec une membrane aux pores bien visibles;
• un cytoplasme limité par une membrane plasmique régulière;
• des mitochondries peu nombreuses (petites et arrondies);
• un ergastoplasme assez abondant
• Le glycogène et les inclusions lipidiques sont rares.
- Cytophysiologie
• Les ostéocytes sont capables de mobiliser le phosphate de calcium sur la surface de la lacune, ceci représente une quantité importante de sels minéraux rapidement échangeables.
• L’ostéocyte est une cellule métaboliquement active, mais les échanges nutritifs par les canalicules restent néanmoins difficiles.
• L’ostéocyte n’a pas la capacité de se diviser, d’autant que la rigidité et l’imperméabilité de la matrice extracellulaire s’y opposent.
• Elle joue un rôle dans le renouvellement et l’entretien de la matrice osseuse.
2-2-4- Ostéoclastes
Tout au long de la vie adulte, l’os subit un processus continu de remodelage interne et de renouvellement qui comprend l’élimination de la substance fondamentale et son remplacement par l’os récemment déposé. Dans ce processus les agents de résorption
osseuse sont les ostéoclastes, occupant des cavités superficielles sur la surface osseuse,
appelées lacune de Howship
- Microscopie optique
• Ce sont des cellules osseuses géantes de 50 à 100 μm,
• sont plurinucléés (renfermant 30 à 50 noyaux);
• comportent un cytoplasme acidophile, bourré de granules et de vacuoles;
• de la famille des macrophages, capables de détruire la matrice minéralisée.
• Localisée à la surface de l’os.
• disposées à la surface des travées osseuses en voie de résorption.
• sont hautement mobiles capables de se déplacer à la surface des travées osseuses d'un site
de résorption à un autre.

- Microscopie électronique
Au contact de l’os, la surface cellulaire présente une bordure en
brosse, ce sont de longues expansions irrégulières se terminant au contact de lysosomes et de
vacuoles de sécrétion. A ce niveau, des pompes à protons relarguent des ions H+ dans le
milieu extracellulaire, solubilisant ainsi les cristaux minéraux. La bordure en brosse occupe
une surface limitée, mais un ostéoclaste peut en posséder plusieurs. Elle révèle :
• un noyau à double membrane, irrégulier;
• un cytoplasme avec de nombreuses mitochondries (riche en crêtes), peu de réticulum
endoplasmique granuleux, quelques agrégats de ribosomes ainsi que des lysosomes (+++)
- Cytophysiologie
L’ostéoclaste sécrèterait des acides faibles (acides lactiques, acide
citrique), solubilisant les cristaux minéraux (sels de calcium) dans le milieu extracellulaire. Le
collagène est digéré dans les vacuoles cellulaires par une collagénase. L’ostéoclaste est une
cellule d’origine hématopoïétique dérivant des cellules monocytaires, assurant les fonctions
suivantes:
* La déminéralisation du tissu osseux.
* La dégradation de la trame organique. Le
déficit en ostéoclastes est responsable de l’ostéoporose congénitale, actuellement curable par
greffe de moelle.
3- ossification
C’est un processus de construction des tissus osseux. Il existe deux grands types d’ossification
L’apposition osseuse s’effectue toujours dans une zone ou préexiste :
- Soit un tissu conjonctif très riche en collagène
● ossification de membrane : pour la formation des os plats
● ossification périostique : pour la formation de la diaphyse des os longs
- Soit du cartilage : ossification enchondrale (endochondrale)
Il s’agit dans tous les cas d’une ossification primaire
- Soit une couche de tissu osseux déjà formé :
● Résorption et Construction = Remodelage Osseux
S’effectuent en même temps au cours du développement et de la croissance osseuse
mais aussi à un degré moindre tout au long de la vie c’est ce qu’on appelle le
remodelage osseux.
Ces deux activités opposées mais complémentaires conduisent :
- au maintien de la masse osseuse
- rôles métaboliques et de soutien : libération et stockage des sels minéraux
Il s’agit d’une ossification secondaire
3-1- Ossification de membrane
- Tissu osseux se développe à partir d’une membrane fibreuse
- Le tissu osseux dérive directement des cellules mésenchymateuses
- Centres d’ossification très vascularisés
- Survient lors du développement des os plats.

4-2- Ossification enchondrale ou cartilagineuse
L’ossification se fait à partir du cartilage hyalin : L’ossification enchondrale se développe à
partir d’un centre d’ossification diaphysaire puis se poursuit au niveau des deux centres
d’ossification épiphysaire.
Au niveau des cartilages de conjugaison métaphysaire des os longs: la croissance en longueur
des os est assurée (les cartilages de conjugaison sont situés entre la métaphyse et l’épiphyse
des os longs).
3-2-1- l’ossification diaphysaire
Au niveau diaphysaire, au centre, suite à la pénétration vasculaire, un premier centre
d’ossification apparaît :
- les chondrocytes deviennent globuleux et hypertrophiés, avec un cytoplasme qui se charge
de glycogène, de lipides et des phosphatases alcalines; ils deviennent vacuolaires par la suite
et finissent par dégénérer.
- Les chondroplastes augmentent de volume en même temps que les cellules, aux dépens de la
matrice interterritoriale cartilagineuse qui est réduite à de très minces travées irrégulières, qui
se chargent de calcium et de phosphastases.
- Le cartilage, qui n'était pas vascularisé, est pénétré par des vaisseaux sanguins qui se
capillarisent au niveau des cellules hypertrophiées. Ces capillaires sont accompagnés de tissu
conjonctif, contenant des cellules conjonctives peu différenciées ou préostéoblastes.
- Les pré-ostéoblastes détruisent la paroi des chondroplastes et se différencient en
ostéoblastes qui vont élaborer de la matrice osseuse et constituer un os primaire.
- L'ensemble de ces phénomènes constitue la pré-ossification, qui va se développer et
progresser de façon ordonnée.
Au niveau diaphysaire, en périphérie, une ossification primaire endomembranaire a lieu dite
ossification périostique. Elle permettra la formation d’une gaine osseuse ou virole périostique
(os primaire primitif non lamellaire).
3-2-2- l’ossification épiphysaire
Au niveau des deux épiphyses, la pénétration vasculaire, induit la formation de deux centres
d’ossification épiphysaire suivant les mêmes étapes décrites précédemment aboutissant à la
constitution d’un os primaire au niveau des deux épiphyses.
En conclusion, en passant progressivement du cartilage vers l’os, on rencontre donc
successivement les zones suivantes dans la plaque de croissance:
♦ une zone de cartilage hyalin plus ou moins importante selon le degré de croissance de l’os ;
♦ une zone de cartilage sérié ou les chondrocytes se multiplient activement ;
♦ une zone de cartilage hypertrophié ;
♦ une zone de cartilage calcifié ou les cellules sont en voie de nécrose ;
♦ une zone de cartilage érodé, où des chondroclastes amenés par des bourgeons conjonctivovasculaires
creusent des lacunes qui seront envahies par les précurseurs de la moelle osseuse hématopoïétique ;
♦ une zone d’ossification où les travées cartilagineuses ayant échappé à l’érosion servent de
guide au dépôt d’ostéoblastes. Ces derniers sécrètent une matrice pré-osseuse qui va
rapidement se minéraliser.



-Remodelage osseux
Le squelette adulte se renouvelle en permanence. Ce remodelage est assuré par deux types cellulaires, les ostéoclastes qui résorbent la matrice osseuse et les ostéoblastes qui synthétisent une nouvelle matrice.
Le mécanisme cellulaire de renouvellement du tissu osseux est soumis à l'influence de
facteurs exogènes et endogènes dont les plus importants, capables de moduler l'activité des
cellules osseuses, sont des facteurs hormonaux et locaux ainsi que les contraintes mécaniques.
(Les hormones calciotropes PTH, vitamine D et calcitonine) modulent le remodelage osseux,
soit directement, soit en modifiant la production des facteurs locaux de régulation du
métabolisme osseux. Elle se déroule en plusieurs phases
4-1- Phase quiesciente
La surface osseuse est normalement recouverte de cellules bordantes qui empêchent l’accès
des ostéoclastes à la matrice extracellulaire(MEC)
4-2- Phase d’activation
Sous l’action de facteurs ostéorésorbants (hormone parathyroïdienne ou PTH, vitamine D3
et prostaglandine), les cellules bordantes se rétractent et libèrent l’accès aux ostéoclastes qui
peuvent adhérer à la matrice osseuse
4-3- Phase de résorption
Pendant laquelle sont générés les ostéoclastes, qui détruisent la matrice osseuse pendant la
phase de résorption avant d’entrer en apoptose.
Chaque ostéoclaste devenu actif se fixe à la matrice sur le lieu de résorption et la phase de
résorption de la matrice commence. Elle s’effectue en deux étapes successives :
1) dissolution de la phase minérale par acidification du compartiment de résorption,
2) dégradation de la matrice organique sous l’action d’enzymes protéolytiques lysosomales.
4-4- Phase d’inversion
Pendant cette phase les ostéoblastes sont générés puis prennent place dans la cavité précédemment creusée par les ostéoclastes.
4-6- Phase de formation ou de reconstruction
Au cours de cette phase une matrice organique est déposée par les ostéoblastes. S'ensuivra alors la
minéralisation de la matrice osseuse.
5- les types d’articulations
On distingue quatre types d’articulation :, les synarthroses, les amphyarthroses et les diarthroses.
- Les Synarthroses: (articulations fixes) Ce sont des os qui sont engrenés ensembles (os du crâne).
- Les amphiarthroses: Ce sont des articulations peu mobiles dans lesquelles les deux surfaces osseuses sont unies par les éléments fibreux très courts ne permettant pas que des déplacements réduits.
- Les diarthroses: Ce sont les articulations les plus typiques. Elles sont constituées par
des surfaces articulaires réunies par des moyens d’union (capsules et ligaments) et
mobiles l’une par rapport à un organe de glissement (la synoviale).
TISSU SANGUIN
1. Introduction
Le sang est un 'tissu mésenchymateux' (= tissu conjonctif spécialisé). Il est contenu dans les vaisseaux sanguins.
Le sang comprend le plasma (55%) et les éléments figurés (45%).
Le plasma est constitué de protéines (albumine, globulines), d'enzymes, de lipides, de glucides, d'ions et de sels minéraux, de vitamines, de gaz dissous et d'eau.
Les éléments figures du sang regroupent 4 types de cellules :
● Les globules rouges (ou hématies ou érythrocytes)
● Les globules blancs (ou leucocytes)
● Les plaquettes (ou thrombocytes)
● Les réticulocytes
2. Origine et devenir des cellules sanguines
Toutes les cellules sanguines sont issues de la moelle hématopoïétique, elles sont issues de cellules souches multipotentes.
Les cellules sanguines rejoignent ensuite le compartiment sanguin.
Certaines d'entre elles gagnent différents organes où elles exercent leurs différentes fonctions :
-- Les lymphocytes T immatures gagnent le thymus pour leur maturation, ils rejoindront ensuite les organes lymphoïdes secondaires (rate, ganglions) pour y exercer leurs fonctions ;
-- les lymphocytes B gagnent directement les organes lymphoïdes secondaires.
On retrouve également des lymphocytes au niveau des tissus conjonctifs.
→ Les granulocytes et les monocytes sont retrouvés au niveau des tissus conjonctifs.
3- Globules rouges et réticulocytes
3-1- Introduction
– Les globules rouges sont également appelés érythrocytes ou hématies.
– Ils ont pour origine la moelle hématopoïétique. Ils dérivent d'une cellule souche multipotente qui donne une cellule souche myéloïde.
– Les réticulocytes sont les formes jeunes des globules rouges.
– Durée de vie = 120 jours.
– Leur déstruction physiologique a lieu dans la moelle hématopoïétique, la rate et le foie.
– L'extravasation des globules rouges hors du compartiment vasculaire est pathologique.
3-2- Propriétés et fonctions
● Mobilité
Les hématies n’ont pas de mobilité propre ; leur déplacement est purement passif en fonction du courant sanguin.
● Plasticité et élasticité.
Ces propriétés permettent aux hématies de s’étirer et ainsi de passer dans des capillaires de calibre très étroit et de reprendre, après une déformation temporaire, leur aspect normal.
●L’agrégation
Les hématies ne demeurent pas isolées mais ont tendance de s’accoler par leurs faces, formant ainsi des rouleaux. Ce phénomène est réversible. De cette propriété découle l’examen de la vitesse de sédimentation (VS)
● L’agglutination
Dans certaines conditions, les hématies peuvent s’accoler les unes aux autres mais de façon irréversible. Cette agglutination est due à la formation de complexes antigènes –anticorps (découverte des groupes sanguins).
– naturellement rouges à cause de l'hémoglobine qu'ils contiennent et donnent ainsi au sang sa couleur.
Le transport de l'oxygène et du gaz carbonique se fait par l'intermédiaire de l'hémoglobine. L'hémoglobine est formée de globine, protéine associée à quatre groupements hème. Chaque hème associe un noyau porphyrique à un atome de fer ferreux.
3-3- Microscopie optique
Les GR sont des cellules anucléées (sans noyau). Sur une coloration au MGG, ils apparaissent rose-orange, on dit que ce sont des cellules acidophiles. Cette coloration est plus intense en périphérie.
Les réticulocytes ne sont pas visibles au MGG.
Il faut donc les visualiser avec une coloration spéciale : le bleu de Crésyl. On observe des
débris nucléaires.
3-4- Microscopie électronique à balayage
Les globules rouges apparaissent sous la forme d'un disque biconcave.
C'est cette forme particulière qui explique que la coloration en périphérie soit
plus intense que la coloration centrale (épaisseur plus importante en périphérie).
3-5-Numération des globules rouges
Elle s’exprime en nombre de cellules par litre de sang (ou en nb/mm³).
Attention il faut connaître l’unité : 1012/L de sang ou 106/ mm³.
S’il y a une diminution du nombre de globules rouges, on parle d’anémie. Dans le cas contraire, on parle de polyglobulie.
3-6-Taille du globule rouge
- Homme, chien : 7 μm de diamètre
- Chat, cheval, bovin : 6 μm
- Ovin : 4,5μm
- Caprin : 3μm
4- Les globules blancs

4-1- Introduction
Les globules blancs sont aussi appelés leucocytes. Ils comprennent les leucocytes granuleux (appelés également granulocytes ou polynucléaires) et les leucocytes hyalins.
Les leucocytes hyalins sont divisés en 2 groupes : les lymphocytes (B, T et cellules NK) et les monocytes.
– Toutes ces cellules ont pour origine la moelle hématopoïétique.
Les leucocytes sont issus d'une cellule souche multipotente qui donne naissance à une cellule souche lymphoïde (CFU-L) pour tous les lymphocytes, et une cellule souche myéloïde (CFU-GEMM) pour tous les granulocytes et les monocytes (NB: c'est la même cellule souche que pour les GR et les plaquettes).
4-2- Fonctions
Ils participent aux réactions immunitaires innées et acquises des phénomènes inflammatoires que l'organisme a normalement développés pour se défendre contre les agents pathogènes (bactéries, virus, parasites...).
4-3- Les granulocytes
Les granulocytes comprennent les neutrophiles, les éosinophiles et les basophiles. Ces cellules ont des propriétés tinctoriales différentes.
Remarque : le terme ≪polynucléaires≫ pour désigner les granulocytes est un terme impropre car ces cellules possèdent un noyau unique mais polylobé.
4-3-1-Caracteristiques communes
● Noyau:
– polylobé : les lobes sont relies entre eux par de fins ponts de chromatine.
– la chromatine des lobes est dense, bien colorée au MGG
● Cytoplasme : présence de granulations
4-3-2-Fonctions
La fonction principale des granulocytes est la défense de l'organisme contre les
agents pathogènes :
- bactéries mais aussi de nombreux virus pour les neutrophiles
- vers parasites (helminthes) pour les éosinophiles
- parasites pour les basophiles.
4-3-3-les granulocytes neutrophiles
Ils sont également appelés polynucléaires neutrophiles (PNN).
– origine : la moelle hématopoïétique. 90% des neutrophiles sont en réserve
dans la moelle hématopoïétique
– sang : 10% de tous les neutrophiles sont dans la circulation sanguine, leur
demi-vie est de 6 à 8 heures.
● Microscopie optique:

– taille : 12 a 14 μm
– noyau polylobe : 3 à 5
– cytoplasme éosinophile avec granulations
azurophiles et neutrophiles (spécifiques)
Chez le chien, le chat, les ruminants et le cheval, les
granulations sont difficiles à voir. Dans tous les cas
le noyau est à chromatine dense.
● Microscopie électronique

Le noyau a une chromatine dense,
le cytoplasme
contient deux types de granulations : les granulations
non spécifiques ou primaires, azurophiles qui
renferment une myélopéroxydase, des hydrolases acides
et du lysosyme et des granulations spécifiques
secondaires, neutrophiles, de petite taille (0,3 à 0,8 μm)
éparses dans le cytoplasme.
Valeurs chiffrées :
Quand on s’intéresse à un hémogramme, il faut utiliser les nombres absolus (pas les pourcentages).
Pour le chien, on a en gros 70% de GNN soit 3000-11500/mm3
Chez les bovins, on a 28% de GNN soit 600-4000/mm3
Le chat, 35 à 75% soit 2500-12500/mm3
Le Chien : entre 3000 et 11500/mm3
Les PNN sont capables de traverser la paroi endothéliale diapédèse
Les PNN sont capables de phagocytose.
Les polynucléaires neutrophiles jouent un rôle de phagocytose, interviennent dans les processus d’infections bactériennes et dans les réactions inflammatoires provoquées par l’accumulation de microbes, de toxines et de débris cellulaires. Ils sont très mobiles, se déplacent par les pseudopodes comme les amibes. Ils ont la possibilité de traverser la paroi des capillaires sanguins (diapédèse) pour passer dans les tissus, y exercer leur fonction et y mourir. Les polynucléaires neutrophiles ont une durée de vie courte (3 à 4 jours). Ils sont incapables de se diviser.

4-3-4- Les granulocytes éosinophiles
Ils sont également appelés les polynucléaires éosinophiles (PNE).
– origine : moelle hématopoïétique
– Fonction :
► phagocytose moindre que les neutrophiles
► Destruction des organismes trop volumineux pour être phagocytes
Les PNE, tout comme les PNN, sont mobiles et capables de phagocytose.
Ils interviennent également dans la défense de l’organisme pour lutter contre les parasites. Ces granulocytes effectuent la diapédèse. Leur durée de vie varie de 8 à 10 jours et ils sont incapables de se diviser.
● Microscopie optique
Taille : 10 a 14 μm
– noyau bilobé
– grosses granulations rose orangées
– granulations azurophiles.
● Microscopie électronique:
Les granulations spécifiques, éosinophiles sont volumineuses, de 0,5 à 1,5 μm de diamètre et contiennent une matrice granulaire au sein de laquelle se trouve une formation cristalloïde allongée. Ces granulations contiennent une péroxydase (différente de la myélopéroxydase des neutrophiles) et des hydrolases acides.

● Caractéristiques selon les espèces :
Homme et bovin : granulations rondes de taille moyenne, nombreuses et parfois superposées au noyau.

Cheval : il a les plus grosses granulations. Elles peuvent être ovalaires et parfois cachent le noyau
Chat : Ces granulations sont nombreuses en forme de bâtonnets
Chien : Granulations de forme variable, pas très souvent rondes, de taille différente. Il peut y en avoir beaucoup comme pas beaucoup. Le fond cytoplasmique n’est pas blanc à la différence des autres espèces mais légèrement basophile avec des vacuoles optiquement vides, spécifiques du chien.
Valeur chiffrée :
Ce sont des cellules qui sont peu rencontrées.
Chien : entre 100 et 1250/mm3
Chat de 0 à 1500/mm3
Idem pour les bovins et le cheval.
4-3-5- Les granulocytes basophiles
Ils sont également appelés polynucléaires basophiles.
– origine : moelle hématopoïétique ;
– fonctions : défense de l'organisme contre certains parasites, manifestations
allergiques via leurs récepteurs aux IgE de haute affinité et leur contenu en
histamine.
Ils peuvent effectuer la diapédèse. Leur durée de vie varie de 12 à 15 jours et ils
sont également incapables de se diviser.
● Microscopie optique
– taille : 10 a 14 μm
– noyau peu segmente
– grosses granulations violettes masquant le noyau

● Microscopie électronique
– grosses granulations, 0,2 à 1 μm de diamètre
Caractéristiques par espèces :
Cheval : noyau bilobé, granulation basophile que l’on voit superposées au noyau. Idem chez Bovin, ovin, caprin et homme.
Chien : quelques petites granulations basophiles sur un fond cellulaire légèrement grisé.
Chat : granulations très nombreuses en forme de grain de riz non basophile car sont bleues lilas ou bleues lavande.
Valeurs chiffrées :
Cheval : 0-280/mm3
Bovin 0-200 /mm3
4-3-6- Les monocytes
– origine : moelle hématopoïétique ;
– durée de vie : environ 24h dans le sang
– passent dans les tissus pour devenir des macrophages
-- Fonctions
Phagocytose des bactéries, corps étrangers, cellules vieillissantes, débris, etc...
Ils participent activement dans la défense de l’organisme.
● Microscopie optique:
– taille : 15 à 20 μm
– noyau excentrique

C’est la plus grosse des cellules sanguines.
Elle mesure 25 à 30 μm de diamètre. Elles
sont comparables quel que soit l’espèce
animale.
Le noyau est aussi énorme, mais son rapport nucléo-plasmique (RNP) est plus
faible que pour les lymphocytes car il y a plus de cytoplasme.
● Microscopie électronique:

la chromatine est fine, les organites bien développés et situés dans l'encoche du noyau.
Il existe de nombreuses granulations azurophiles, de petite taille correspondant à des lysosomes.
La membrane plasmique est
irrégulière avec de nombreuse expansions et microvillosités.
Les monocytes représentent 2 à 10 % de l'ensemble des globules
blancs.
Il s’appelle monocyte dans le sang et dès qu’il passe dans les tissus, il s’appelle macrophage.
4-3-7- Les lymphocytes
Ils sont impliqués dans l'immunité dite acquise ou adaptative et présentent toujours à leur surface un récepteur aux antigènes.
On distingue 2 grandes sous-populations de lymphocytes : les lymphocytes B et les lymphocytes T.
Les propriétés de diapédèse sont marquées, par contre la phagocytose est nulle.
● Microscopie optique:
Ce sont des cellules de petites tailles, environ 7 μm de diamètre avec un noyau occupant la quasi-totalité de la cellule. Leur forme est régulière et arrondie.


● Microscopie électronique

– rapport nucléo-cytoplasmique élevé
– noyau parfois encoche, a chromatine dense, absence de
nucléole.
Ce sont des cellules mononuclées. Il existe des petits
lymphocytes de taille comparable à celle des hématies (6
à 9 microns) et des grands lymphocytes, beaucoup plus
grands donc (10 à 15 microns).
Le rapport nucléo
plasmique est très élevé c’est-à-dire qu’il y a un gros noyau et très peu de
cytoplasme.
Données numériques :
On en trouve : - Chien = 20%
- Chat = 32%
- Cheval = 39%
- Bovin = 58%br
5- Les plaquettes
Elles sont également appelées thrombocytes.
5-1- Origine et fonctions
– origine : moelle hématopoïétique
– durée de vie : 8 a 12 jours
– fonctions : les plaquettes patrouillent à la recherche de lésions endothéliales et
en cas de lésion elles entrainent la formation du thrombus blanc (1er stade de la
coagulation sanguine) et la rétraction du caillot (fin du processus de
coagulation).
● Microscopie optique
– taille : 2 a 4 μm
– absence de noyau
– cytoplasme constitué par le hyalomère
périphérique qui est transparent et hyalin et
par le granulomère ou chronomère
central, coloré et azurophile

● Microscopie électronique
Granulomère
Il contient 4 types de granulations :
– granules denses
– granules clairs
– lysosomes
– peroxysomes
Hyalomère
Il comporte un système de canalicules qui sont ouverts à la surface de la
membrane plaquettaire.
Ce sont les plus petits éléments sanguins que l’on peut trouver. Ils font entre 1,5
et 4,5 μm de diamètre.
Il existe des formes géantes que l’on retrouve dans toutes les espèces, mais
surtout chez les carnivores. Elles peuvent être alors aussi grandes qu’une
hématie. Ça arrive plus souvent si ce sont de jeunes plaquettes activées.
On peut
observer ces formes géantes dans le cas de thrombopénie régénérative. En effet,
la moelle produit beaucoup de plaquettes jeunes dans le sang pour essayer de
compenser la perte.
On peut observer aussi des agrégats le plus souvent chez le porc et le chat qui
sont des artéfacts de prélèvement. Une plaquette s’agrège très vite si on la sort
de son milieu. Si on fait un prélèvement sur une petite espèce animale, les
plaquettes vont coller dans l’aiguille et pas dans le tube. Ce phénomène est très
exacerbé chez le chat où l’on trouve souvent des agrégats plaquettaires.
L'hématopoïèse
Définition.
L'hématopoïèse est l'ensemble des phénomènes qui concourent à la fabrication et au remplacement continu et régulé des cellules sanguines.
L'hématopoïèse débute classiquement au cours du développement foetal dans le sac vitellin : il est ensuite possible d'observer les cellules hématopoïétiques dans les espaces sinusoïdaux entre les travées hépatocytaires puis dans la rate. Au cinquième mois, la moelle osseuse commence à produire des leucocytes et des plaquettes et plus tardivement des globules rouges.
A la naissance, la moelle osseuse est le siège principal de la production hématopoïétique.
Chez l'adulte, seule la moelle osseuse des vertèbres, des côtes, du crâne, du bassin et de la partie proximale du fémur assure le renouvellement des lignées sanguines.
On distingue deux grands axes de différenciation :
- La cellule souche lymphoïde qui donnera naissance aux lymphocytes
- La cellule souche myéloïde commune pour les lignées érythrocytaires, granulocytaires et mégacaryocytaires.
1- LA LIGNÉE ÉRYTHROPOÏÉTIQUE
Les lignées sanguines On peut déterminer, dans cette lignée une série de stade arbitrairement définis qui vont donner naissance au globule rouge à partir d'une cellule souche d'aspect indifférencié sensible à l'érythropoïétine.
Des modifications morphologiques et biochimiques permettent de décrire les stades de proérythroblaste (1), d'érythroblaste basophike (2), d'érythroblaste polychromatophile (3), d'érythroblaste orthochromatophile (4) puis de réticulocyte (5). Six jours environ sont nécessaires pour qu'un proérythroblaste devienne un globule rouge circulant.
`
Au cours de cette maturation,
● Les cellules vont diminuer de taille (de 25 μm pour le proérythroblaste à environ 8 μm pour le réticulocyte) ;
● Le noyau a une taille de plus en plus petite et une chromatine de plus en plus condensée ;
● l'hémoglobine apparaît au stade de polychromatophile puis augmente progressivement.
● Le noyau est expulsé au stade d'orthochromatophile qui devient réticulocyte. Le réticulocyte contient quelques ribosomes et des mitochondries qui donnent au cytoplasme un aspect plus violacé au MGG que celui du globule rouge.
2- LA LIGNÉE MYÉLOPOÏÉTIQUE
Sous l'influence de facteurs stimulants notamment le CSF (Colony Stimulating Factor), la cellule souche se différencie en myéloblaste.
Les différentes étapes de maturation vont donner naissance au promyélocyte, au myélocyte puis au polynucléaire.
–
Les transformations morphologiques et biochimiques de ces stades sont les suivantes :
● La taille de la cellule diminue (de 25 μm à 12 μm) ;
● Le noyau, arrondi dans le myéloblaste, est légèrement concave dans le promyélocyte puis devient réniforme dans le métamyélocyte ;
● Des granulations azurophiles, primaires, apparaissent au stade de myéloblaste et deviennent très nombreuses dans le promyélocyte ;
● Les granulations spécifiques apparaissent au stade de promyélocyte. De ce fait, on distingue, à partir de ce stade les lignées neutrophile, éosinophile et basophile facilement reconnaissables à leurs granulations spécifiques.
3- LA LIGNÉE MÉGACARYOCYTAIRE
L'aspect morphologique permet de distinguer trois étapes de maturation :
● Le mégacaryoblaste
● Le mégacaryocyte granuleux
● Le mégacaryocyte thrombocytaire. La lignée mégacaryocytaire Les plaquettes sanguines proviennent de la fragmentation cytoplasmique de ces mégacaryocytes médullaires arrivés à maturité.
Au cours de la maturation,
● La taille de la cellule augmente (de 30 μm à 100 μm)
● Le noyau est d'abord indenté puis plurilobé
● Les granulations cytoplasmiques sont de plus en plus nombreuses ; des grains de sérotonine apparaissent dans la cellule mature.
● Les microfilaments et les microtubules sont présents à tous les stades de maturation.


QUESTION 1.
Choisir l'information correcte relative au tissu cartilagineux : (Le tissu cartilagineux est un tissus non vascularisé et non innervé)(!La substance fondamentale du cartilage, basophile, PAS +; mais non métachromatique, est composée de chondronectine, entre autre)(!Au cours de la croissance interstitielle, les cellules cartilagineuses forment des constituants de la matrice avant de se diviser)(!En situation normale, les chondrocytes ont une forme étoilée au sein des chondroplastes -logettes contenant les chondroblastes-)(! Sur une coupe histologique du pavillon de l'oreille, observée au microscope électronique après coloration à l'orcétine, les fibres élastiques composant ce cartilage deviennent visibles)
QUESTION 2.
Choisir l'information correcte relative au tissu cartilagineux (! La substance fondamentale du cartilage permet de résister aux forces de pression grâce à des protéoglycanes comme la chondronectine)(En microscopie optique, les capsules entourant les chondrocytes sont colorées grâce à la présence de glycoaminoglycanes)(!Les disques intervertébraux sont des exemples de cartilage élastique, visible en microscopie optique après coloration à la fuschine résorcine)(!Le cartilage hyalin présent au niveau du squelette foetal est un cartilage vascularisé mais non innervé)
QUESTION 3.
Choisir l'information correcte relative au tissu osseux: (! Environ 60% du volume de l'os spongieux constitue la matrice de l'os)(!De l'extérieur vers l'intérieur, les os courts sont constitués de la table externe, la table interne et la diploé)(!L'ostéoclasie est assurée par des cellules polarisées appelées ostéocytes)(!L'os spongieux se situe généralement à la partie diaphysaire des os longs)(Les ostéoclastes, issus des phagocytes mononucléés assurent la destruction du tissu osseux)
QUESTION 4.
Choisir l'information correcte relative au sang (! Lymphocytes 6000/mm3)(Polynucléaires éosinophiles 100/mm3)(!Polynucléaires neutrophiles 12000/mm3)(!Globules rouges 4,8 x10^6/mm3)(!Globules blancs 20000/mm3)
QUESTION 5.
Choisir l'information correcte relative au sang: ( 90% des lymphocytes sont observés sous forme de petits lymphocytes de 6 à 9 µ de diamètre.)(! Les organes lymphoïdes contiennent peu de lymphocytes)(!Le cytoplasme basophile des petis lymphocytes est colorable en bleu gris 'ciel d'orage)(!Les lymphocytes ont pour rôle majeur; la défense aspécifique de l'organisme)(!Les lymphocytes mémoires sont des lymphocytes à vie courte mais permettant une réponse immunitaire rapide)
QUESTION 6.
Choisir l'information correcte relative au tissu musculaire: (!On rencontre des cellules musculaires groupées au niveau de l'aréole du mamelon)(!Les cellules musculaires peuvent former des tuniques avec une partie lohgitudinale située à l'intérieur d'une circulaire externe)(!Les cellules musculaires lisses, hors les cellules des structures vasculaires, possèdent des filaments intermédiaires de desmine et de vimentine)(Les cellules musculaires lisses peuvent être isolées dans un tissu ou regroupées pour former un véritable muscle comme le muscle érecteur des poils)(!Les cellules musculaires)
QUESTION 7.
Les caractéristiques de l'ossification endomembraneuse : (Les corticales situées de part et d'autre de la dentelle osseuse sont formées dans un deuxième temps)(Les travées sont progressivement formées par action des ostéoblates et des ostéoclastes)(Elle évolue vers la dentelle osseuse qui correspond à des travées osseuses anatomosées)(Les espaces situés entre les travées seront ensuite occupés par la moelle osseuse)(!Les ostéocytes synthétisent la substance osseuse et deviennent ostéoblastes)
QUESTION 8.
Concernant les ostéoclastes : (!Ils n'existent que dans l'os immature)(Ils participent au remodelage avec les ostéoblastes)(Ils sont doués de résorption par dissolution des sels de calcium)(Ils créent les lacunes d'Howship)(Ce sont des cellules géantes multinucléées)
QUESTION 9.
Les caractéristiques de l'ossification endochondrale : (!Les travées cartilagineuses servent de support aux ostéoclastes)(!Elle démarre au niveau des épiphyses)(Le bourgeon conjonctivo-vasculaire qui pénêtre dans la maquette cartilagineuse apporte les futurs ostéoblastes)(Il se produit une prolifération des chondrocytes suivie de leur hypertrophie)(Les premiers éléments osseux qui apparaissent sont au niveau du périoste)
QUESTION 10.
Os compact lamellaire: (!Les ostéones sont formés de lamelles concentriques ente lesquelles se trouvent des ostéoblastes)(Les cellules osseuses des ostéones possèdent de longs prolongements qui les relient aux cellules voisines)(Ce tissu osseux compact forme la diaphyse des os longs)(!IChaque ostéone est creusé d'un canal central : le canal de Volkmann)(C'est un tissu dense formé de structures cylindriques : les ostéones)
QUESTION 11.
Concernant le périoste : (Il est formé par des fibroblastes qui se différencient en ostéoblastes)(!Il permet la croissance de l'os en longueur)(Il correspond à un os compact)(!C'est un tissu conjonctif dense dont la partie externe est ostéogène)(Il est formé par un phénomène d'ossification endomembraneuse)
QUESTION 12.
Ossification endochondrale: (Les espaces situés entre les travées calcifiées sont occupés par des bourgeons conjonctivo-vasculaires)(Les chondrocytes hypertrophiés dégénèrent à proximité du front d'érosion)(!Le cartilage hyalin se transforme en cartilage hypertrophié puis en cartilage sérié)(!Cette photographie correspond à l'ossification de la voûte du crâne)(On peut observer le front d'érosion, limite du cartilage calcifié)
QUESTION 13.
Concernant les ostéoblastes : (!Ils sont habituellement plurinucléés)(!Ils sont actifs dans la résorption osseuse)(!On les observe entre les lamelles des systèmes haversiens)(Ils élaborent la bordure ostéoide)(Ils sont alignés le long des travées osseuses)
QUESTION 14.
Les caractéristiques du tissu osseux : (Il peut être lamellaire)(!Ce tissu peut être trabéculaire ou compact et n'est pas vascularisé)(Les ostéoclastes peuvent être visualisés en périphérie des travées osseuses)(C'est un tissu conjonctif spécialisé avec une substance fondamentale minéralisée)(!Les cellules du tissu osseux comportent notamment des chondroblastes)
QUESTION 15.
L'ossification endomembranaire ou endomembraneuse : (Ce sont des cellules mésenchymateuses qui se différencient en ostéoblastes)(!Elle peut concerner les épiphyses des os longs)(Les points d'ossification sont remodelés par les ostéoblastes et les ostéoclastes)(!Elle commence par la formation de points d'ossification au sein du cartilage)(Elle concerne les os plats)
QCMs DU CONCOURS de PHARMACIE, ACCES DEUG. HISTOLOGIE
QUESTION Q3. (Rabat 2016).
La matrice extracellulaire -MEC-:
(!Est un composant fait exclusivement de fibres)(!Son
origine embryonnaire est ectoblastique)(La fibronectine de la MEC intervient dans l'adhérence cellulaire et la transduction des signaux)(Le collagène représente le système de fibres le plus abondant dans la MEC)
QUESTION Q4. (Rabat 2016).
Les molécules d'adhérence cellulaire -Cell Adhesion Molecules, CAM-:
(Le domaine cytosolique des cadhérines est associé à des caténines avant la liaison au cytosquelette)(!Les desmogléines et les desmocollines sont des intégrines)(Assurent la reconnaissance spécifique entre deux cellules ou entre cellules et MEC)(Les immunoglobulines N-CAM ne font pas partie de ces molécules)
QUESTION Q5. (Rabat 2016).
Les desmosomes de type maculaire:
(!Est un système d'adhésion -ancrage- entre la cellule et la lame basale)(!Ce système est indépendant du cytosquelette cellulaire)(La desmoplakine sert d'attache aux cadhérines transmembranaires)(!Les cellules myocardiques en sont dépourvues)
QUESTION Q11. (Rabat 2016).
L'ossification:
(L'os est formé de collagène de type 1 à 90%)(Il est formé d'hydroxyapatite, de calcium et de phosphore)(L'ossification membranaire est responsable de la formation de la diaphyse des os longs)(!Les lacunes de Howship sont produites par l'action des ostéoblastes)
QUESTION Q12. (Rabat 2016).
Les cellules musculaires cardiaques:
(!Possèdent plusieus noyaux en position périphérique)(!On
décrit une plaque motrice pour chaque millier de cellules)(!La contraction musculaire est volontaire)(La contraction de ces cellules est calcium dépendante)
QUESTION Q13. (Rabat 2016).
La myéline:
(!Les cellules de Schwann sont responsables de la myélinisation du système nerveux central)(La conduction de l'influx nerveux le long de la gaine de myéline est saltatoire)(!Seules les dendrites sont myélinisées)(!La myélinisation du SNC se continue jusqu'à l'enfance)
QUESTION Q29. (Rabat 2022).
En ce qui concerne les épithéliums:
(Les mésothéliums forment la paroi des cavités fermées.)(!Les endothéliums tapissent la paroi des sereuses.)(!L'épithéium pseudostratifié est formé de plusieurs couches.)(Ils peuvent être classés en fonction de la présence de quelques différentiations de la surface des cellules épithéliales.)
QUESTION Q30. (Rabat 2022).
Cochez la ou les proposition(s) juste(s):
(Au niveau de l'intestin, la cellule calciforme joue le rôle d'une glande exocrine unicellulaire.)(Les épithéliums peuvent être classés en fonction de la présence de quelques différenciations de la surface des cellules épithéliales)(!Les glandes intraépithéliales -endoépithéliales- possèdent toujours un canal excréteur.)(Lors de l'excrétion holocrine, la cellule subit une dégénérescence qui aboutit à la rupture de ses membranes et à la libération du composant accumulé.)
QUESTION Q31. (Rabat 2022).
A propos des cellules suivantes:
(!Le fibrocyte est une cellule faiblement mobile.)(!L'adipocyte est une cellule très passive, son métabolisme est très lent.)(Le macrophage prend le nom du microglie au niveau du tissue nerveux central.)(!Le macrophage prend le nom cellule du Kupffer au niveau du tissue osseux.)
QUESTION Q32. (Rabat 2022).
Veuillez cocher les propositions justes:
(!L'acide hyaluronique est un glycoaminoglycane sulfaté.)(!Au niveau des fibres de collagène, un tiers des acides aminés correspond à la proline, hydoxyproline, lysine et hydroxylysine.)(Le tissu osseux réticulaire est un tissu osseux primaire.)(!Le procollagène est constitué d'une double hélice.)
QUESTION Q33. (Rabat 2022).
Au niveau du tissu nerveux central:
(Le corps de Nissl correspond à un amas de ribosomes libres dans le cytoplasme de la cellule nerveuse.)(!L'oligodendrocyte fait partie de la névroglie épithéliale.)(Les microgliocytes peuvent se transformer en macrophages en cas de lésion.)(!Au niveau du neurone, le prolongement axonique est toujours unique.)
QUESTION Q34. (Rabat 2022).
En ce qui concerne le tissu musculaire:
(La cellule musculaire squelettique dérive des myotomes.)(!Les cellules musculaire squelettiques se divisent en cas de lésion du muscle.)(!La cellule musculaire cardiaque est multinucléé.)(Au niveau du muscle cardiaque, les traits scalariformes correspondent à des systèmes de jonctions entre les cellules.)
QUESTION Q35. (Rabat 2022).
En ce qui concerne le tissu sanguin:
(Au niveau des polynucléaires, les granulations primaires sont riches en peroxydases.)(!Un unité d'hémoglobine peu transporter 2 molécules de O2.)(!Les lymphocytes B sont responsable de l'immunité cellulaire.)(Les lymphocytes B effectuent leur différenciation au niveau de la moelle osseuse.)
QUESTION Q16. (Marrakech 2024).
Les cellules de l'épithélium de revêtement:
(Sont unies par des systèmes de jonctions.)(!Reposent directement sur le tissu conjonctif.)(Peuvent être munies de cils vibratiles)(Peuvent être responsables de la fonction d'absorption.)(Reçoivent les nutriments à travers la membrane basale.)
QUESTION Q17. (Marrakech 2024).
Les tissus fondamentaux sont:
(Le tissu épithélial.)(Le tissu conjonctif.)(Le tissu musculaire.)(Le tissu nerveux.)(!Le tissu osseux.)
QUESTION Q18. (Marrakech 2024).
Les épithéliums de revêtement:
(!Renferment des fibroblastes.)(Sont non vascularisés.)(Peuvent être des épithélium pseudostratifiés.)(Peuvent contenir des cellules glandulaires.)(!Sont de renouvellement inconstant.)
QUESTION Q19. (Marrakech 2024).
Les glandes endocrines:
(sécrètent des hormones.)(!sécrètent des produits séreux.)(!sécrètent des produits muqueux.)(Sont dépourvues d'un canal excréteur.)(Peuvent avoir une architecture vésiculaire.)
QUESTION Q20. (Marrakech 2024).
Parmi les modes de sécrétion des glandes exocrines, on distingue:
(Le mode apocrine.)(Le mode merocrine.)(Par diffusion.)(!Par endocytose.)(Le mode holocrine.)
QUESTION Q21. (Marrakech 2024).
La classification des glandes exocrines repose sur:
(!La nature du produit secrété.)(Le mécanisme de vidange.)(L'architecture de la glande.)(!La présence ou non du canal excréteur.)(!La morphologie.)
QUESTION Q22. (Marrakech 2024).
Les fibres de réticuline:
(!Sont synthétisées par les histocytes.)(Sont des fibres longues et minces.)(Présentent des striations transversales.)(!Peuvent se ramifier.)(On les trouve au niveau des paroi des vaisseaux.)
QUESTION Q23. (Marrakech 2024).
Le fibroblaste:
(Comporte des prolongements.)(!Est pauvre en organites.)(Peut avoir un aspect fusiforme.)(Dérive de cellules mésenchymateuses.)(Est responsable de la synthèse de la matrice extracellulaire.)
QUESTION Q24. (Marrakech 2024).
Les cellules fixes du tissu conjonctif sont les:
(Fibroblastes)(!Monocytes.)(Adipocytes.)(!Fibrocytes)(!Lymphocytes)
QUESTION Q25. (Marrakech 2024).
Parmi les glandes suivantes, lequel est amphicrine homotypique?
(!Glandes mammaires.)(!Glandes lacrymales.)(!Glandes sudoripares.)(!Thyroïde)(Foie)
QUESTION Q26. (Marrakech 2024).
Parmi les propositions suivantes, lesquelles correspondent aux cardiomyocytes ? (!Les cellules sont fusiformes)(!Les noyaux sont périphériques.)(Les stries scalariformes.)(La présence de la triade.)(!L'absence de citernes terminales.)
QUESTION Q27. (Marrakech 2024).
Les fibres élastiques: (!Sont synthétisées par les histiocytes.)(Sont des fibres longues et minces.)(!Présentent des striations transversales.)(Peuvent se ramifier.)(On les retrouve au niveau de la paroi des vaisseaux)
QUESTION Q28. (Marrakech 2024).
Les cellules musculaires lisses: (Sont des cellules allongées fusiformes)(!Sont beaucoup plus grosse que les cellules musculaires striées.)(!Ont une membrane plasmique faite de nombreux tubules T.)(Ont un noyau unique central.)(Renferment des myofilaments d'actine et de myosine.)
QUESTION Q29. (Marrakech 2024).
Le tissu osseux: (Est une forme spécialisée du tissu conjonctf.)(Est un des tissus les plus durs de l'organisme et il bénéficie d'un remodelage.)(!Est constitué uniquement de cellules appelées les ostéoblastes.)(Constitue un lieu d'échange, en particulier de calcium et de phosphore.)(!Est non vascularisé.)
QUESTION Q30. (Marrakech 2024).
Les ostéocytes: (!Sont pauvres en organites.)(!Synthétisent les fibres de collagène type I.)(Comportent des prolongements.)(Sont des cellules définitives.)(!Dérivent des ostéoclastes.)
REVISIONS: LISTE GENERALE --- ADHERENCE et COMMUNICATION CELLULAIRE --- TISSU EPITHELIAL --- TISSU CONJONCTIF --- TISSU MUSCULAIRE --- TISSU NERVEUX ---